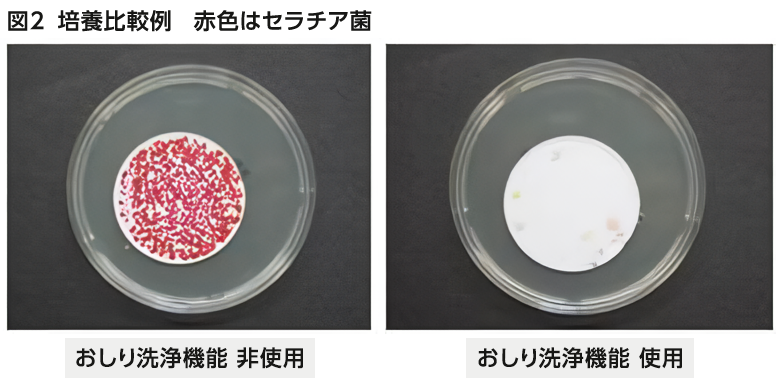

感染症の予防と消毒・滅菌の専門研究者による
研究成果の説明
日本レストルーム工業会では、第一線で活躍される感染症の予防と消毒・滅菌を専門とされる研究者に温水洗浄便座の使用と手指衛生について、調査研究を委託しました。
その研究結果は概要として掲載していますが、その内容をもっと分りやすく説明する記事をご執筆して頂きました。

感染防止に貢献
-おしり洗浄機能の使用で、手指汚染菌が大幅に減少-

山陽小野田市立山口東京理科大学薬学部教授、東京医療保健大学大学院客員教授。一般社団法人日本環境感染学会総会2012年度大会長。専門は院内感染の原因究明や、病院内の衛生管理。『消毒と滅菌のガイドライン』『病棟で使える消毒・滅菌ブック』『消毒薬の選び方・使い方』などの著書をもち、医学会や厚生省等行政機関のガイドライン制作等に尽力している。
1.手指に糞便由来の微生物が付着すると・・・
排便の際に手指に付着した微生物が、食材や環境などを介して他のヒトの口に入ると、腸管感染症の原因になり得ることが分かっています。ノロウイルス胃腸炎、腸管出血性大腸菌感染症、赤痢、コレラ、A型肝炎などの種々の腸管感染症が生じるのです。
たとえば、ノロウイルス不顕性感染(感染はしているが無症状)の食品取扱者が、食パンの検品時にノロウイルスを付着させてしまい、それを給食で食べた1271名もの生徒がノロウイルス胃腸炎を発症した事例があります(イラスト1.)。
イラスト1. 排便後の手洗い不十分で、1271名ものノロウイルス胃腸炎患者が発生した。

なお、トイレットペーパーの重ね枚数ですが、排便後には4枚重ねで拭くヒトがもっとも多いことが分かっています。(グラフ1. イラスト2.)
グラフ1. は + をクリック
グラフ1. お尻を拭くときに使用するトイレットペーパーの重ね枚数(日本レストルーム工業会)
【男女計 温水洗浄便座使用者・不使用者計 シングル・ダブル計 n=1,748】

イラスト2. トイレットペーパー4枚重ね

しかし、4枚重ねでは糞便中の微生物は容易に通過できるのです。なぜなら、4枚重ねであっても細菌の100倍ほどの大きさの穴が多数あいているからです(図1)。
図1. 4枚重ねのトイレットペーパーの顕微鏡写真(×35)
0.1㎜ほどの穴(細菌の100倍ほどの大きさの穴)が多数あいている。

2.排便後の手指付着菌は、トイレの洗浄機能の使用で大幅に低下!
トイレのおしり洗浄機能を使用すると、使用しない場合に比べて、排便後の手指汚染菌が大幅に低下することが判明しました(Oie
et al. Japanese Journal of Infectious Disease 2018年, Oie et al.
Journal of Water Health 2022年)。
はじめに、お尻模型とセラチア菌を混ぜた人工便を使って排便後の状態を模擬して拭き取り試験を行い、どのくらい菌が手に付くかを調べました。その結果、おしり洗浄機能を使った場合では使わない場合に比べて手に付く菌数が1万分の1以下になることがわかりました(図2)。
次に、32名の看護学生の協力で、おしり洗浄機能の使用の有無による排便後の手指付着菌量を調べたところ、平均値が非使用時で39,499個/手指、使用時で4,146個/手指との結果が出ました(表1)。おしり洗浄機能の使用で、手指汚染菌は約1/10に低下したのです。なお、今回の研究では、おしりの洗浄時間や水勢(強・中・弱)は各個人に任せています。
結果の表1は + をクリック
表1.おしり洗浄機能の使用の有無による手指の微生物汚染*1
| 参加者 番号 | 菌数/手指 | 性別 | おしり洗浄機能の水勢 | おしり洗浄機能の使用時間(秒) | |
|---|---|---|---|---|---|
| おしり洗浄機能を非使用(cfu*3/手袋) | おしり洗浄機能を使用(cfu*3/手袋) | ||||
| 1 | 4.1×105 | 5.4×104 | 男 | 強 | 30 |
| 2 | 1.7×105 | 664 | 男 | 弱 | 30 |
| 3 | 1.0×105 | 3.4×104 | 男 | 弱 | 80 |
| 4 | 8.5×104 | 2.4×104 | 男 | 中 | 30 |
| 5 | 7.8×104 | 131 | 男 | 強 | 20 |
| 6 | 7.2×104 | 115 | 女 | 中 | 5 |
| 7 | 7.1×104 | 328 | 女 | 弱 | 30 |
| 8 | 5.6×104 | 38 | 女 | 中 | 15 |
| 9 | 2.4×104 | 310 | 男 | 強 | 30 |
| 10 | 2.4×104 | 720 | 男 | 中 | 30 |
| 11 | 2.2×104 | 5 | 男 | 中 | 10 |
| 12 | 2.1×104 | 7.2×103 | 男 | 中 | 25 |
| 13 | 1.8×104 | 352 | 女 | 中 | 10 |
| 14 | 1.7×104 | 816 | 女 | 中 | 30 |
| 15 | 1.7×104 | 4.8×103 | 男 | 中 | 15 |
| 16 | 1.5×104 | 1.0×103 | 男 | 強 | 30 |
| 17 | 1.4×104 | 420 | 男 | 中 | 30 |
| 18 | 1.1×104 | 66 | 男 | 強 | 45 |
| 19 | 1.0×104 | 134 | 男 | 中 | 60 |
| 20 | 7.0×103 | 1.5×103 | 女 | 弱 | 40 |
| 21 | 5.0×103 | 848 | 女 | 強 | 30 |
| 22 | 4.0×103 | 172 | 女 | 弱 | 30 |
| 23 | 4.0×103 | 360 | 男 | 中 | 10 |
| 24 | 2.0×103 | 38 | 男 | 強 | 20 |
| 25 | 2.0×103 | 15 | 女 | 中 | 20 |
| 26 | 2.0×103 | 63 | 男 | 中 | 30 |
| 27 | 1.0×103 | 29 | 女 | 弱 | 30 |
| 28 | 1.0×103 | 265 | 女 | 中 | 50 |
| 29 | 320 | 97 | 女 | 中 | 24 |
| 30 | 244 | 18 | 女 | 弱 | 60 |
| 31 | 228 | 124 | 女 | 中 | 30 |
| 32 | 184 | 75 | 女 | 中 | 20 |
| 平均±標準偏差 *2 | 39,499.3 ± 77,768.3 | 4,146.9 ± 11,427.7 | |||
*1 排便後は4枚重ねのトイレットペーパーを用いた.また,2重手袋の外側の手袋の汚染について調べた.
*2 有意差あり〔p<0.00001(Wilcoxon signed-rank test)〕
*3 Colony Forming Unit(コロニー フォーミング ユニット)の略 細菌を培地で培養し,
できたコロニー(集団)数
研究結果の概要紹介ページはコチラから
3.おしり洗浄機能は公衆衛生の向上に寄与
排便後には十分な手洗いを行うのが原則ですが、手洗いが十分でなかったり、正しい手洗いの仕方でなかったりする場合が少なくありません。したがって、糞便由来の微生物の手指付着を大幅に減少させることができるおしり洗浄機能は、手指衛生の助っ人ともいえます(イラスト3)。今後、おしり洗浄機能が世界中で普及すると、公衆衛生の向上に大きく寄与すると考えられます。
イラスト3. おしり洗浄機能の使用では、手指付着菌は大幅に低下する。

参考文献
1)土屋祐司,佐原篤,神保達也,他.パンを原因としたノロウイルス集団食中毒事例.日本食品微生物学会誌.32:153-158, 2015.
2) Oie S, Aoshika H, Arita E, Kamiya A. The use of electric toilet seats with water spray is efficacious in maintaining hand hygiene in experimental model. Jpn J Infect Dis. 71: 306-308, 2018.
3) Oie S, Kawai S. Microbial contamination of hands with or without the use of bidet toilets (electric toilet seats with water spray) after defecation. J Water Health. 20: 21-71-275, 2022
日本レストルーム工業会からの情報
1.温水洗浄便座の使用とトイレットペーパーの使用に関する実態調査について
委託研究では、日本レストルーム工業会の「温水洗浄便座の使用とトイレットペーパーの使用に関する実態調査」で調べた最も多い4枚重ね(4つ折り)で行われました。調査には、「トイレットペーパーの種類(シングル・ダブル)」、「拭き方(重ね派・丸め派)」などもあります。調査結果をぜひご覧ください。

2.手指への細菌付着数と手洗いについて
委託研究結果によると、温水洗浄便座のおしり洗浄をしなかった場合では、手指に付着した細菌数は、最大で105cfu/手袋でした。トイレを使用しておしりをペーパーで拭くと細菌やウイルスが手指に付着すると考えられます。手を洗うまでに触れた箇所も同様です。細菌やウイルスを広げないようトイレを出る前には必ず手洗いを行うことが大切です。手洗いと手指消毒のポイントについてはこちらをご覧ください。
